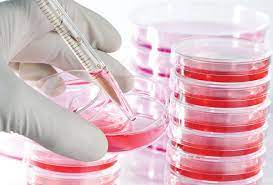
Teknik Kultur In Vitro Hewan BIT 2023

Enrolment options
Deskripsi Mata Kuliah:
Mata kuliah ini membahas tentang definisi, prinsip/ konsep, sejarah dan perkembangan penemuan/ riset teknik kultur in vitro hewan, biologi sel, jaringan dan organ pada kondisi in vitro, teknik aseptis/ sterilisasi, penyiapan dan pembuatan medium, teknik kultur primer organ, jaringan, sel; teknik pembuatan cell line; teknik mengidentifikasi dan karakterisasi cell line, teknik induksi kultur sel; teknik pemeliharaan dan preservasi sel, tipe kultur dan aplikasinya dalam bidang biomedis, bioteknologi dan biologi perkembangan, permasalahan dan pemecahannya.
Capaian Pembelajaran Lulusan:
Setelah menempuh mata kuliah Tehnik Kultur In Vitro Hewan, mahasiswa mampu menjelaskan dan mengidentifikasi biologi sel, jaringan dan organ hewan pada kondisi in vitro, merancang teknik-teknik kultur in vitro pada hewan, mengetahui tipe-tipe kultur in vitro hewan dan aplikasinya dalam bidang biomedis, bioteknologi dan biologi perkembangan.
- Teacher: Dzul Fithria Mumtazah
- Teacher: nuning nurcahyani
- Teacher: primasari.pertiwi primasari.pertiwi
- Teacher: Endang L. Widiastuti
- Enrolled students: 54